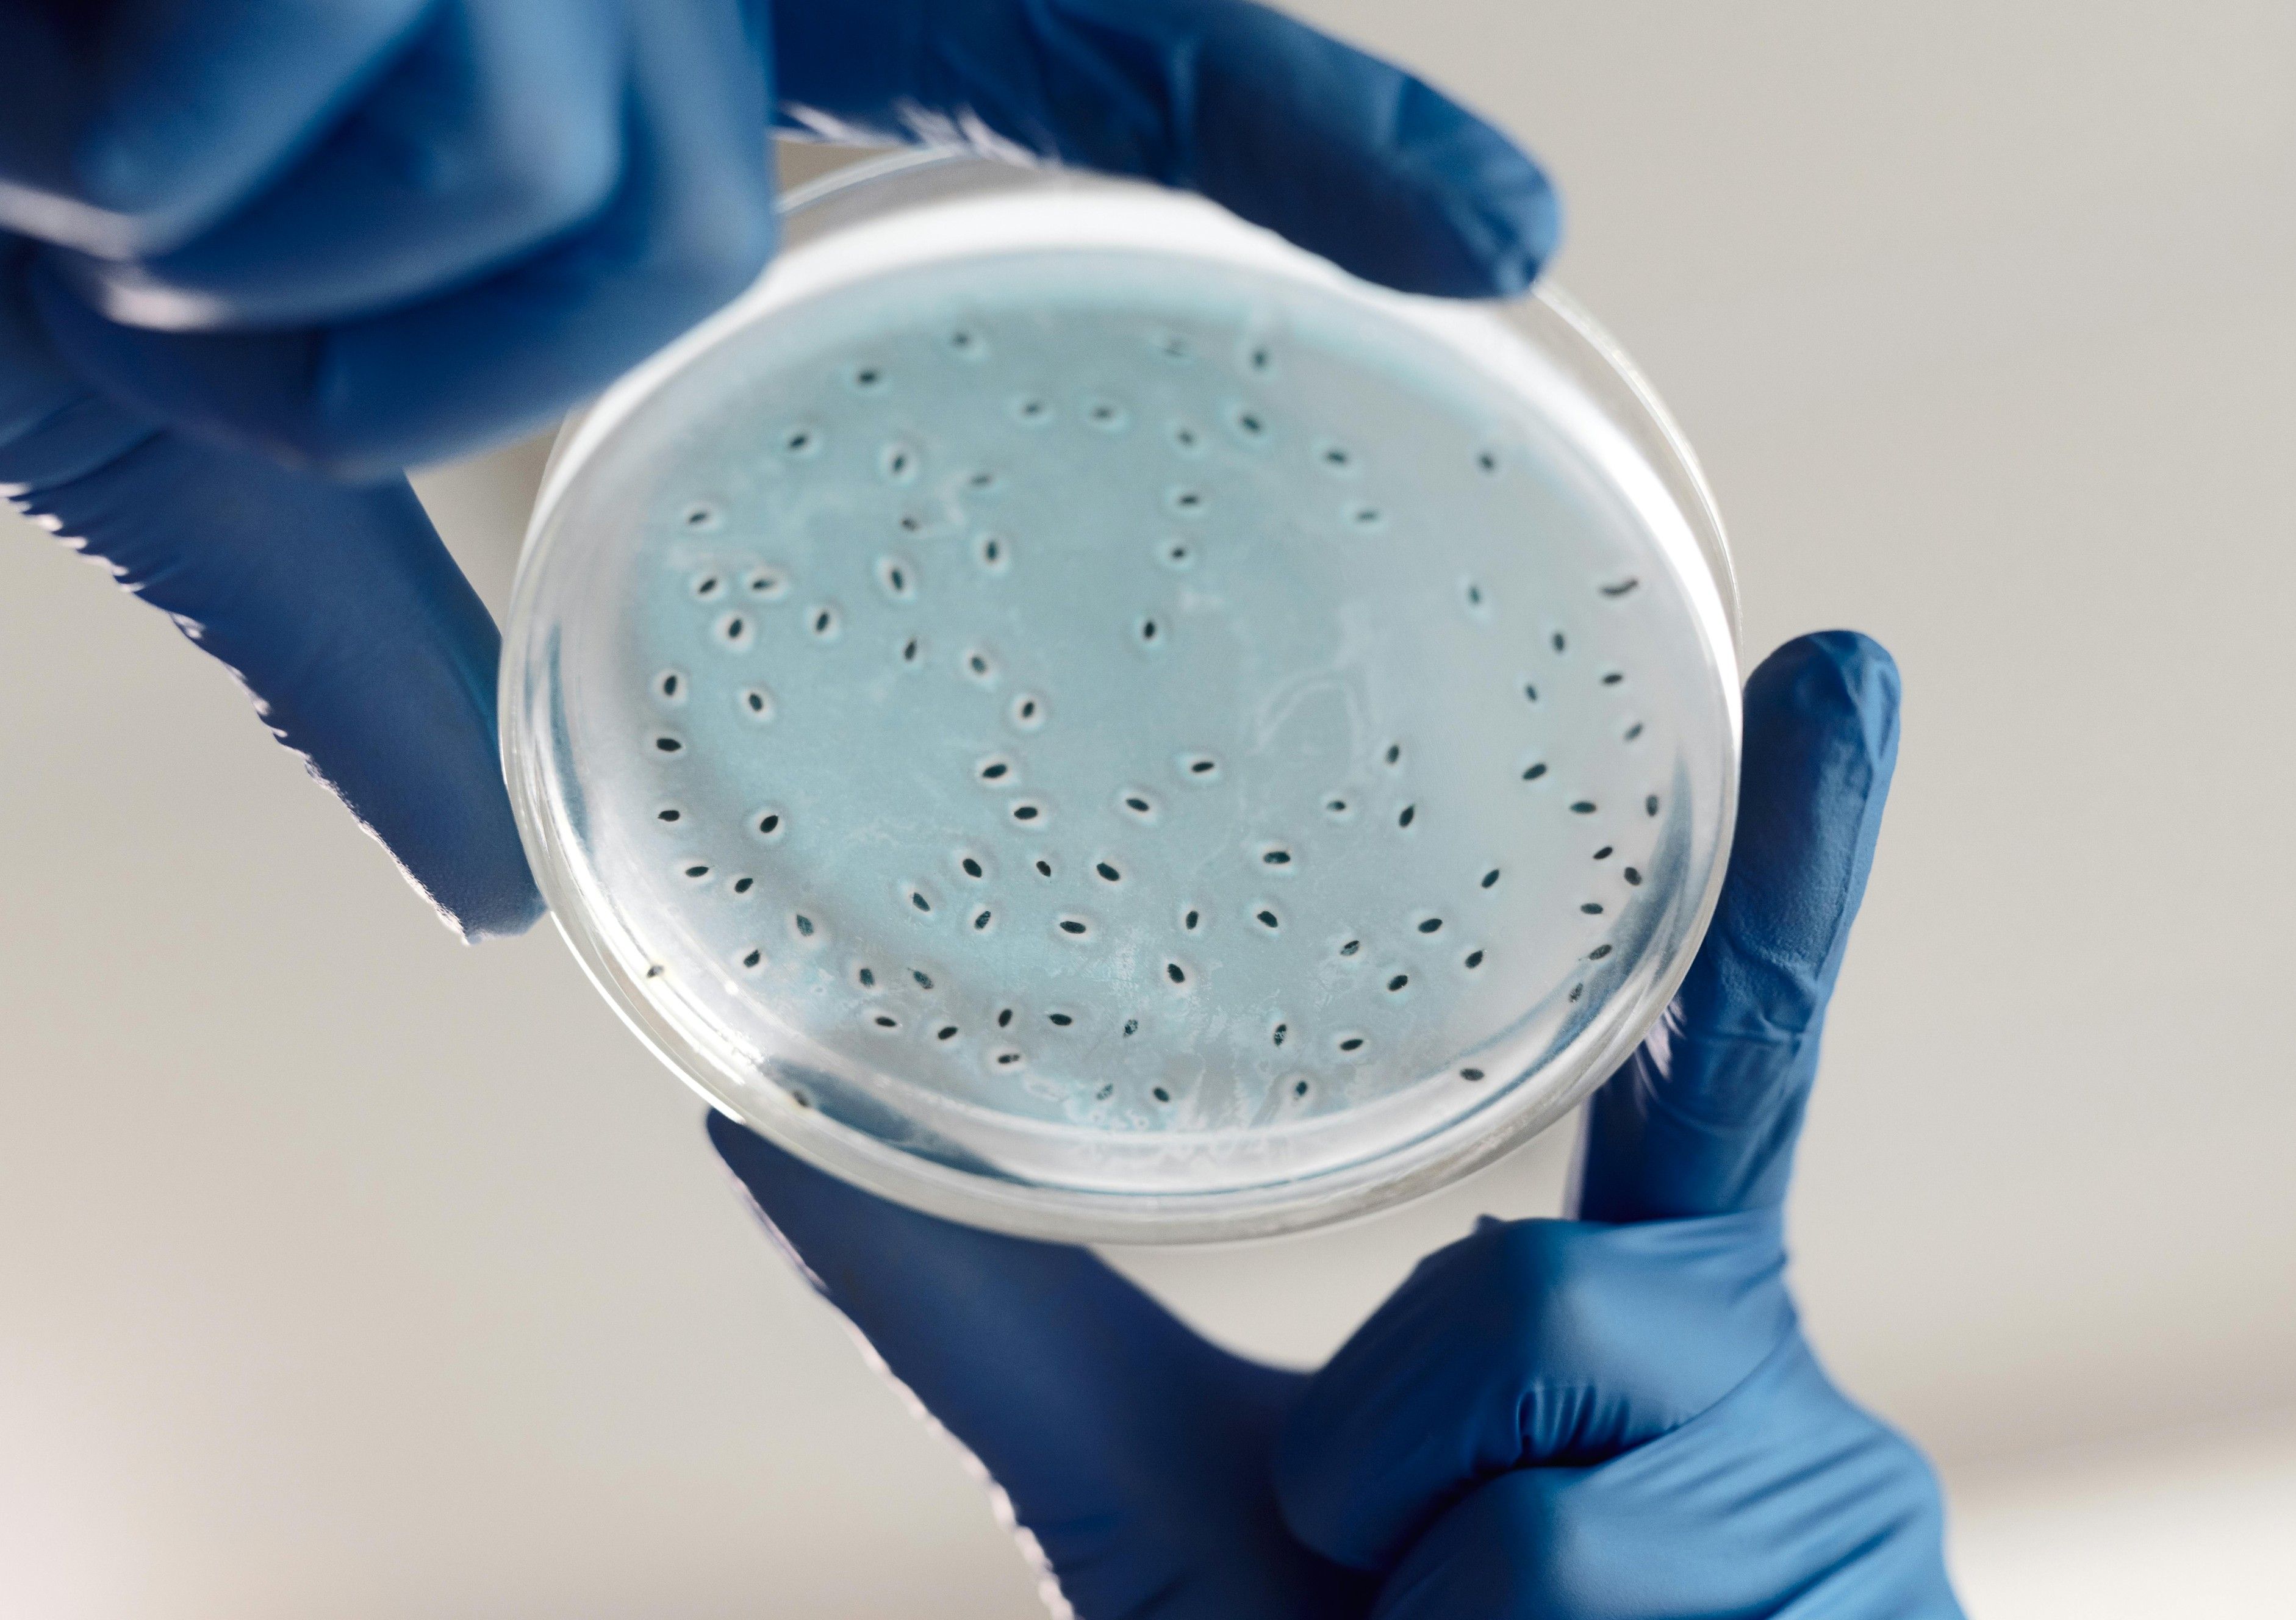
Make informed and intelligent decisions based on data

Life sciences
Life sciences, accelerated
Turning data into scientific progress
The life sciences sector is under pressure to move faster, work more efficiently, and make better use of increasingly complex data, from research and development to clinical trials and market access.
We work with life sciences organisations to apply data and AI where it can make a real difference: improving research efficiency, accelerating clinical development, and supporting better decision-making across the value chain. The result is work that supports scientific progress and, ultimately, leads to better outcomes for patients—without losing sight of regulatory requirements, data privacy, or operational reality.
Contact us to discuss the possibilities and start your journey towards maximising the impact of data and AI in the healthcare or life sciences industry.
























Clinical data
Life sciences organisations often work with clinical data spread across studies, systems, and formats. We help bring this data together in a consistent, usable way, enabling teams to combine historical clinical data, integrate multiple data modalities (including imaging and omics), and create a reliable foundation for analysis. This supports biomarker discovery, improves clinical trial design, and enables more robust comparisons between treatments to inform research and market access decisions.

Clinical trials and research
The drive to bring new drugs to market quickly is often slowed by the challenge of prolonged timelines in research and clinical development. We help life sciences teams significantly decrease the time to market by leveraging synthetic data to simulate patients before clinical trials, in addition to integrating AI and analytics platforms for secondary use of clinical data. The result is faster drug market entry, more efficient processes, and reduced cost across research and trials.

Data-driven decisions
In a world inundated with information, insights can be hard to extract. We help tame the data overload by utilising LLMs to surface and deliver precise insights to researchers, medical writers, and market-access professionals. From tracking scientific developments to navigating patents and competitive landscapes, our approach supports clearer, more confident decision-making.
Prediction models
Predictive models play an increasing role across life sciences, from research and development to downstream planning. We design, build, and maintain models that are grounded in domain expertise and fit for operational use. By combining data science with sector knowledge, we help organisations improve efficiency, manage resources more effectively, and support better outcomes across the life sciences value chain.


AI that holds up in the real world
We help organisations turn data and AI into working systems, not proofs of concept. From defining where AI adds real value to building the foundations that make it stick, we deliver solutions that inform decisions and predict what comes next.
About us0+
Countries clients served across
0+
Nationalities on our team
0+
Offices
Life sciences
"I believe that ADC has done a terrific job. They quickly understood the complexities of the UICC organisation, and its structure with members and partners. They have conducted themselves perfectly – really leaving us with great input for our future endeavours. "
Cary Adams
CEO at UICC
Latest insights
Perspectives on data and AI in life sciences, from the people doing the work.

Event: Data Engineering in Research and Development Within Life Sciences
Join us on November 19th to explore data engineering in Research and Early Development (R&ED) within the Life Sciences industry.

Highlights of Denmark’s Inaugural OMOP Roundtable
Insights from the inaugural OMOP Roundtable in Denmark to unite individual efforts in a collaborative network. Sign up to join the next event.

Event: Join Us at the First OMOP Roundtable in Denmark
Join us for the inaugural gathering of the Danish OHDSI community at a roundtable discussing the OMOP and OHDSI methodologies.

Talk to our experts
Let's turn ambition into impact with data and AI.

Life Science Lead
Andreas Kjær

Managing Director, Nordics
Asbjørn Boye Knudsen
Talk to our experts
Let's turn ambition into impact with data and AI.

Life Science Lead
Andreas Kjær

Managing Director, Nordics
Asbjørn Boye Knudsen
Connect with our experts
From shaping an AI vision to scaling solutions in production, we work with you as one team to drive AI transformation that truly brings impact.
Contact us



